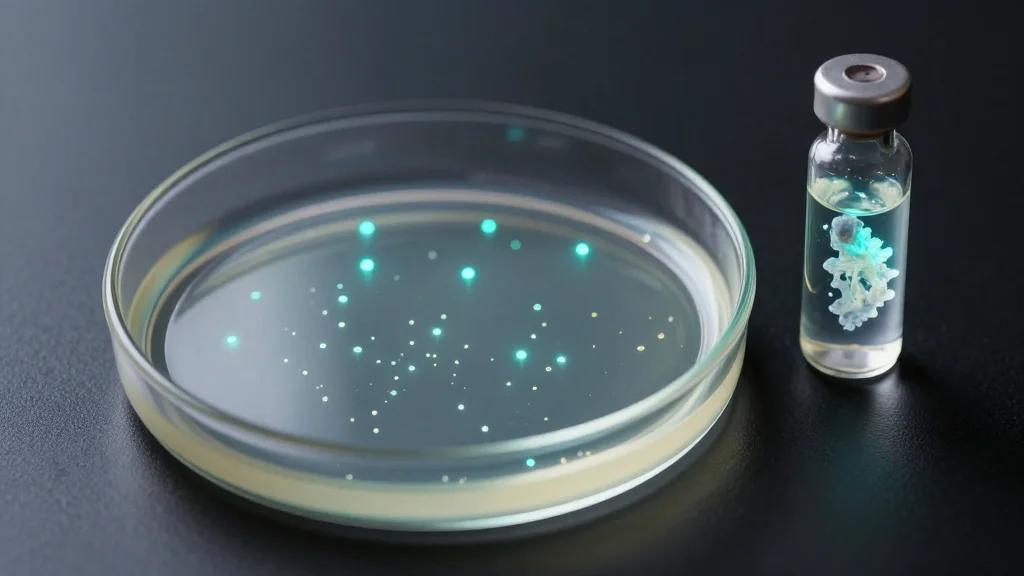
High-Throughput Platform for Fast-Acting Covalent Protein Therapies

NomShub Vulnerability Chain Exposes Hidden Risks in AI Coding Tools
Researchers at Straiker have uncovered a multi‑stage vulnerability chain, dubbed NomShub, in the Cursor AI‑powered code editor. The flaw lets an attacker achieve persistent shell access by simply opening a malicious repository, leveraging prompt injection, a sandbox‑escape in the command parser, and abuse of the tool’s remote‑tunneling feature. No traditional exploit or user‑initiated code execution is required; the AI assistant automatically runs the embedded commands. The discovery highlights how AI‑driven development tools can turn trusted automation into a covert attack vector.

Astronauts Suggest Naming a Moon Crater 'Carroll' After Their Commander's Late Wife
Artemis II astronauts broke the record for the farthest human distance from Earth and became the first crew to see the Moon’s far side. During the historic lunar flyby they identified two unnamed craters and proposed naming them “Integrity” and “Carroll,”...

Joby and Air Space Intelligence Team up to Manage US Electric Air Taxi Skies
Joby Aviation and Air Space Intelligence (ASI) have partnered to embed ASI’s Flyways AI platform into U.S. electric air‑taxi operations, aiming to model and manage high‑density eVTOL traffic before commercial service begins later this year. The collaboration leverages ASI’s 4‑D...

Starlink and the Monopoly Trap: Is Commercial Broadband From Space Already a Closed Market?
Starlink now operates over 6,000 low‑Earth‑orbit satellites, serving roughly 4‑5 million users and generating more than $6 billion in annual revenue. Its vertical integration, in‑house launch capability, and early spectrum filings create a structural moat that rivals such as OneWeb, Amazon’s Project...

Google Accelerates AI Integration Across Mobile with New Dictation and Maps Enhancements
Google unveiled AI Edge Eloquent, an iOS dictation app that runs offline using Gemma‑based speech‑recognition models. The app can tap Gemini’s cloud AI for enhanced accuracy and lets users edit transcripts into various formats. Simultaneously, Google integrated Gemini into Maps to automatically...

Freedom Bank Partners with InvestiFi for Digital Investing
Freedom Bank has teamed up with InvestiFi to embed a full‑service digital investing suite into its online banking platform. The integration lets customers trade stocks, ETFs and digital assets directly from their checking accounts, while also offering Guided Investing portfolios...

NAB Show: Marshall Electronics Bringing CV376 NDI|HX3 HDMI POV Camera
Marshall Electronics unveiled the CV376 Compact NDI|HX3 HDMI POV camera at the NAB Show, featuring an 8.46‑megapixel 1/2.8‑inch sensor capable of 4K 3840 × 2160 p60 output over HDMI and simultaneous IP streaming. The device supports NDI|HX3, NDI|HX2, RTSP and RTMP, with H.264/HEVC encoding...

The Rugged Bose Soundlink Flex Is 25 Percent Off Right Now
Bose has slashed the price of its second‑generation Soundlink Flex portable speaker to $119, a $40 discount from the regular $159 list price. The new Flex retains the original’s rugged IP67‑rated, silicone‑wrapped design and 12‑hour battery life while adding a...

Max Severity Flowise RCE Vulnerability Now Exploited in Attacks
A critical remote code execution flaw, CVE‑2025‑59528, has been confirmed in Flowise, the open‑source low‑code platform for building LLM‑driven applications. The vulnerability allows attackers to inject arbitrary JavaScript through the CustomMCP node, leading to full command execution and file‑system access....

Schools in Knife Crime Hotspots to Get Specialist Training
The UK government will provide specialist training to about 50 of the 250 schools located in knife‑crime hotspots, backed by a £26 million (≈$33 million) Knife Crime Concentrations Fund. It has also shared new mapping technology with 27 police forces that can...

KTC Introduces Master 25M3 24.5-Inch 1440p 320Hz Gaming Monitor
KTC has launched the Master 25M3, a 24.5‑inch gaming monitor that pairs a 2560 × 1440 Fast IPS panel with up to 320 Hz refresh, while its native frequency sits at 300 Hz. Priced around $207, it offers a rare combination of high resolution...

Sprinklr Unveils Spring '26 (26.4) Release
Sprinklr launched its Spring ’26 (26.4) release, adding a suite of AI‑powered features to its Unified‑CXM platform. New capabilities include Customer Feedback Copilot, Marketing Copilot, Autonomous Evaluation, and AI‑driven governance tools that promise more transparent, test‑backed automation. The update also...

From One Demo to Reliable Automation: How GPA Reimagines GUI Process Automation
Salesforce AI Research unveiled GPA, a GUI Process Automation system that learns a workflow from a single human demonstration and replays it with deterministic precision on the local machine. Unlike traditional RPA, GPA avoids brittle scripts, and unlike vision‑language models,...

OptifiNow Integrates with PhoneBurner
OptifiNow, a CRM provider for wholesale mortgage lenders, has launched a two‑way integration with PhoneBurner, a power‑dialer platform. The link lets users push contact lists directly into PhoneBurner for rapid outbound calls and automatically syncs call outcomes back into the...

Segra Launches SkyVoice
Segra, a fiber network provider, has introduced SkyVoice, a unified cloud communications platform that combines voice, collaboration, and contact‑center capabilities. The solution is accessible via desktop and mobile apps and integrates directly with major business systems such as Salesforce, Microsoft...
High-Throughput Platform for Fast-Acting Covalent Protein Therapies
Researchers at Westlake University unveiled a high‑throughput yeast‑surface‑display platform to engineer fast‑acting covalent protein therapeutics. The system screens diverse crosslinkers and millions of protein variants, enabling precise spatial positioning of warheads that dramatically speeds covalent bond formation. Using the platform,...

PAR Technology Announces PAR Intelligence
PAR Technology unveiled PAR Intelligence, an agentic AI layer woven through its restaurant and retail platform. Leveraging two decades of data—including 12 billion annual transactions, 640 million guest profiles, and 400 million loyalty members—the system powers agents that spot performance gaps, auto‑generate offers,...

LiveRamp and Akkio Partner
LiveRamp, a leading data collaboration firm, has teamed up with AI infrastructure provider Akkio to embed Akkio's artificial‑intelligence tools into its platform. The integration adds a conversational AI layer that surfaces media measurement insights in natural language and powers end‑to‑end...

Get More Done with New Vertical Tabs and Immersive Reading Mode in Chrome
Google announced the rollout of two Chrome enhancements aimed at boosting productivity. Users can now enable vertical tabs, moving the tab strip to the side for clearer titles and easier group management. A revamped reading mode offers a full‑page, distraction‑free...

The Insightful Leader Live: AI and Advertising … This Time It’s Personal
Kellogg professors Jacob Teeny and Brett Gordon hosted a free webinar on April 7, 2026 discussing how AI will reshape advertising through hyper‑personalized content. The session covered AI‑driven customer profiling, the latest research on personalized persuasion, emerging industry trends, and the ethical...

Another Chip Shortage Is on the Horizon
AI’s explosive growth is creating a surge in demand for high‑bandwidth memory (HBM), outpacing the supply of both HBM and traditional DRAM. Industry leaders such as SK Hynix and Micron warn that memory shortages could last until 2030, with current...

Voice AI: The Dos, the Don?ts, and What?s Next
Voice AI has reached a maturity level where it can stabilize call‑center workforces by handling after‑hours calls, scheduling, and multilingual support with a word‑error rate under 5 percent. The technology leverages advanced neural networks and large language models to assess urgency,...

Chrome Finally Adds a Better Way to Deal with Too Many Open Tabs
Google Chrome announced the rollout of vertical tabs, moving the tab strip to the side of the browser window for easier title visibility and tab‑group management. The feature can be toggled via a right‑click menu and will stay enabled until...

Energy Storage Pricing Beginning to ‘Fracture’ by Product Type: Report
Anza Renewables reports a widening price gap between U.S. utility‑scale and distribution‑scale energy storage in Q1 2026, with utility‑scale costs dropping up to 20.9% while distribution‑scale prices remain flat around $203/kWh (AC) and $175/kWh (DC). The United States installed a...

Bolt, Facing Financial Struggles, Pivots From Super App to AI
Bolt, the checkout platform that raised nearly $1 billion, has laid off roughly one‑third of its staff and is struggling to meet basic expenses such as AWS fees. Its consumer‑focused super app, launched a year ago, attracted only about 5,000 downloads,...

Walmart to Close Illinois Fulfillment Center
Walmart announced the permanent closure of its Matteson, Illinois fulfillment center, affecting 111 employees. Operations will be transferred to other NextGen facilities in the retailer’s network, and affected workers receive a $7,500 incentive to relocate or transition to open roles....

LG UltraGear EVO GX9 and GM9 Pricing, Specs, and Pre-Order Details
LG has launched two new UltraGear EVO gaming monitors: the 39‑inch OLED GX9 priced at $1,799.99 and the 27‑inch Mini‑LED GM9 at $1,199, both available for pre‑order. Each panel offers a dual‑mode refresh scheme—165 Hz at native 5K resolution and 330 Hz at...

Motivational Composition in Digitally Supported and Conventional Prevention Programs: A Three-Wave Study Based on Self-Determination Theory
A three‑wave quasi‑experimental study compared a digitally supported occupational prevention program with a conventional in‑person format among 163 German employees. While the digital cohort logged significantly higher attendance over 12 and 24 weeks, its Relative Autonomy Index—a measure of autonomous...

Google Starts Showing Sponsored Ads in the Images Tab on Mobile Search
Google has begun serving sponsored ads inside the mobile Images tab, inserting full‑image creatives labeled “Sponsored” directly into the grid. The placement leverages existing image assets from Search or Performance Max campaigns, requiring no changes to keyword targeting or campaign structure....

OpenAI Expands AI Ecosystem with App Integrations, Venture Fund Launch, and Economic Policy Push
OpenAI has added third‑party app integrations to ChatGPT, letting users trigger services such as Spotify directly from the chat interface. Former OpenAI staff launched the Zero Shot venture fund, targeting a $100 million raise to back early‑stage AI startups and already investing...

ASUS Expands ProArt Ecosystem with High-Speed Router and Multi-Gig Switch
ASUS has expanded its ProArt line with the PRT‑BE5000 router and PQG‑U1080 switch, targeting creators who need high‑bandwidth, low‑latency networking. The router delivers dual‑band Wi‑Fi 7 with up to 5 Gbps throughput and dual 2.5 Gbps WAN/LAN ports, while the switch provides eight...

Vertafore Cuts Clicks with Project Impact Workflow Gains
Vertafore’s Project Impact initiative has achieved its target of returning up to two hours a day to account managers by streamlining agency workflows. The program eliminated redundant steps, cut manual work and reduced clicks in high‑volume servicing tasks. Improvements to...

Gilead to Acquire Tubulis for Up to $5B, Expanding Cancer ADC Capabilities
U.S. drugmaker Gilead Sciences announced a definitive agreement to acquire German ADC specialist Tubulis for up to $5 billion, including $3.15 billion upfront cash and up to $1.85 billion in milestones. The acquisition brings Tubulis’ next‑generation antibody‑drug conjugate platform, highlighted by the TUB‑040...

Russian Military Hackers Reroute British Internet Users’ Traffic
Russian military hackers linked to the GRU executed a BGP hijack that rerouted traffic from British internet users to malicious servers. The intrusion affected multiple UK ISPs, exposing users to potential data interception and malware. Network monitoring tools eventually detected...

Forecast-Driven Dynamic Physician Staffing in a Pediatric Emergency Department: A Prospective Quasi-Experimental Pilot Study
A prospective quasi‑experimental pilot at Hacettepe University Children’s Hospital tested forecast‑driven physician scheduling in its pediatric emergency department. Using the TiDE‑RIN deep‑learning demand model and linear programming, daily evening shift staffing was adjusted between three and six physicians. Compared with...

Correlates of Viral Load Suppression Among People Living with HIV on Antiretroviral Treatment in Mbujimayi, Democratic Republic of Congo: A...
A cross‑sectional study of 561 people living with HIV in Mbujimayi, Democratic Republic of Congo identified key behavioral determinants of viral load suppression. Strict antiretroviral therapy (ART) adherence increased suppression odds elevenfold, while having no casual sexual partners doubled the...

One in Five ChatGPT Clicks Go to Google: Study
A Semrush study of over 1 billion U.S. clickstream events shows that Google accounts for 21.6% of all outbound clicks from ChatGPT, making it the single largest referral destination. The top ten domains together receive just over 30% of ChatGPT referrals,...

Pulsed Intra-Arterial Infusion with Synchronously Controlled Blood Flow: A Novel Strategy for Optimizing Intra-Arterial Chemotherapy
Researchers introduced a pulsed intra‑arterial infusion technique with synchronized blood‑flow control (PBC‑IA) to improve chemotherapy delivery. In rabbit models, the method produced more than 20‑fold higher doxorubicin concentrations in the target gastrocnemius muscle compared with standard intravenous injection, while heart...

CRM for Small Business: Benefits, Top Tools, and How to Choose
Choosing a CRM in 2026 is a critical yet daunting task for small businesses constrained by time and budget. This guide outlines essential CRM functions—lead tracking, automation, AI insights—and reviews ten top solutions, including free tiers from HubSpot, Salesforce Starter,...

Most Content Doesn’t Build Credibility: Let’s Fix That
Marketing teams are flooding the market with content, yet most of it fails to earn buyer trust. As AI‑driven research tools synthesize information from multiple sources, they quickly expose generic, self‑referential messaging. Surveys reveal 68% of buyers are more skeptical...

Best Headphone Deals on Sony, Bose, and Beats for April 2026
April 2026 sees deep discounts on top‑tier headphones, with Sony’s WH‑1000XM5 now $248, a near‑record low, and Beats Studio Pro falling to $179.95, delivering premium active‑noise‑cancellation at half price. Bose’s flagship QuietComfort Ultra is reduced to $329, while its mid‑range...

Uber Is the Latest to Be Won over by Amazon’s AI Chips
Uber is expanding its Amazon Web Services contract, adding more Graviton ARM‑based servers and launching a trial of AWS's Trainium3 AI chip. The shift moves additional ride‑sharing workloads from Uber's own data centers and from earlier Oracle and Google agreements...

Bridging the Hybrid Data Gap with ETL Pipelines: A Strategic Approach to Legacy and Cloud Migration
Enterprises operating in hybrid environments face data silos, inconsistent formats, security gaps and costly manual transfers. The article proposes a hybrid data layer powered by automated ETL pipelines as the strategic bridge between on‑premise legacy systems and cloud applications. By...

The New Rules of Engagement: Matching Agentic Attack Speed
AI‑enabled cyberwarfare has moved from theory to reality, highlighted by Anthropic's September 2025 disclosure of an autonomous attack that operated with minimal human input. A 2026 Armis report shows 64% of U.S. IT decision‑makers already suffered AI‑generated attacks, while 92%...

More than a Pretty Picture, Star-Shaped Nanomaterial Changes Energy Storage
University at Buffalo scientists synthesized the first star‑shaped vanadyl hydroxide (VOOH) nanomaterial, converting its electrochemical profile from a bulk‑like battery to a surface‑dominant pseudocapacitor. The transformation occurs over 84 hours as flat sheets evolve into rods and finally six‑armed stars, dramatically...

Navigated TMS Significantly Boosts Combat PTSD Recovery Rates
A randomized clinical trial led by UT Health San Antonio demonstrated that MRI‑guided, robotic‑controlled navigated transcranial magnetic stimulation (TMS) added to intensive psychotherapy produced significant symptom relief for combat‑related PTSD. Eighty‑five percent of participants receiving active navigated TMS showed clinically...

Amagi Launches New Tool to Help Stations Turn Newscasts Into Social Clips
Amagi introduced Newspulse, an AI‑driven platform that turns live and archived news broadcasts into ready‑to‑post social media clips. The system automatically identifies story segments, reformats video into multiple aspect ratios and adds captions and platform‑specific metadata. Human‑in‑the‑loop controls let editors...

Designing Secure & Scalable Healthcare Applications
Healthcare mobile applications are proliferating, but they must balance patient‑data security with the ability to handle surging usage. Developers face three core hurdles: strict HIPAA/GDPR compliance, fragmented interoperability, and the need for elastic performance under heavy loads. Cloud platforms, micro‑service...

Microsoft's Bing Team Open-Sources "Harrier" Embedding Model
Microsoft’s Bing team has open‑sourced an embedding model called Harrier, available in three sizes up to 27 billion parameters. The model supports more than 100 languages, offers a 32,000‑token context window, and was trained on over two billion examples plus synthetic GPT‑5...

NASA to Host Media Call with Artemis II Crew on Way Home From Moon
NASA will host a 20‑minute virtual media call on April 8 at 9:45 p.m. EDT with the Artemis II crew as they travel back toward Earth. The conference, streamed on NASA’s YouTube channel, requires on‑site journalists to RSVP by 1 p.m. that day. Artemis II,...